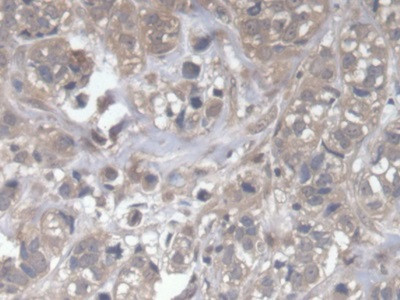
DOCK4 Antibody in Immunohistochemistry (Paraffin) (IHC (P))

Search
Invitrogen
DOCK4 Polyclonal Antibody
{{$productOrderCtrl.translations['antibody.pdp.commerceCard.promotion.promotions']}}
{{$productOrderCtrl.translations['antibody.pdp.commerceCard.promotion.viewpromo']}}
{{$productOrderCtrl.translations['antibody.pdp.commerceCard.promotion.promocode']}}: {{promo.promoCode}} {{promo.promoTitle}} {{promo.promoDescription}}. {{$productOrderCtrl.translations['antibody.pdp.commerceCard.promotion.learnmore']}}
图: 1 / 5
DOCK4 Antibody (PA5-119079) in IHC (P)





Please note: We are reviewing Western blot images included in the antibody testing data in our catalog, including those provided by third parties. Unless expressly labeled or annotated as “raw-unedited”, Western blot images included in the antibody testing data in our catalog may have been edited, optimized or otherwise adjusted for presentation.
产品信息
PA5-119079
种属反应
宿主/亚型
分类
类型
抗原
偶联物
形式
浓度
规格
纯化类型
保存液
内含物
保存条件
运输条件
RRID
靶标信息
The DOCK4 gene encodes the dedicator of cytokinesis 4 protein, a member of the DOCK family, which functions as a guanine nucleotide exchange factor (GEF) for small Rho GTPases, specifically Rac1 and Rap1. DOCK4 is critical for regulating various cellular processes, including cell migration, polarity, and cytoskeletal organization. It plays a significant role in maintaining the integrity of endothelial barriers and mediating intercellular junctions. Mutations or altered expression of DOCK4 have been implicated in cancer progression, particularly in tumor metastasis and invasion, by affecting the adhesion and migration of cancer cells. Additionally, DOCK4 is involved in neurodevelopmental processes and has been associated with psychiatric disorders, reflecting its importance in brain function and development. Understanding the roles of DOCK4 in both health and disease could provide insights into therapeutic strategies for cancer and neurological disorders where these pathways are disrupted.
仅用于科研。不用于诊断过程。未经明确授权不得转售。